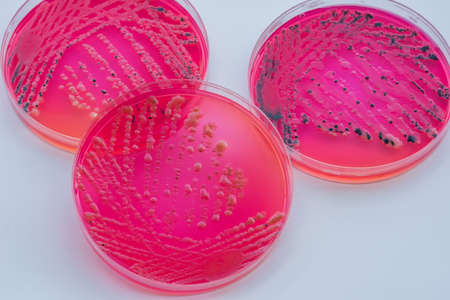
Bacterial colonies culture on  selective agar media XLT Agar (Xylose Lysine Tergitol) contains small light grains. Focus on all agar surface.の写真素材

写真素材 - Bacterial colonies culture on selective agar media XLT Agar (Xylose Lysine Tergitol) contains small light grains. Focus on all agar surface.
作品情報
Bacterial colonies culture on selective agar media XLT Agar (Xylose Lysine Tergitol) contains small light grains. Focus on all agar surface.
- ID:99218858
- 作品種別:写真
- 作者名:Sirirat Makprasert
キーワード
- Media
- agar
- air
- aureus
- background
- bacteria
- bacterial
- bacterium
- biology
- biotechnology
- black
- blood
- cabondioxcine
- cell
- colony
- color
- culture
- danger
- dish
- growth
- health
- healthcare
- hygiene
- isolated
- lab
- laboratory
- medical
- medicine
- medium
- micro
- microbe
- microbiology
- oxidase
- pathogen
- pathogens
- petri
- plate
- plates
- red
- research
- risk
- safety
- science
- scientific
- streak
- test
- treat
- yellow
類似作品
Background with...
Red on a blue. ...
Petri dishes wi...
Backgrounds of ...
Backgrounds of ...
Bacterial cultu...
Backgrounds of ...
Viruses and bac...
Backgrounds of ...
Backgrounds of ...
Petri dishes in...
Gloved hands of...
Backgrounds of ...
Texture of natu...
Backgrounds of ...
Backgrounds of ...
Laboratory tech...
Staphylococcus ...
Staphylococcus ...
Backgrounds of ...
Bacterial colon...
Petri dish with...
Laboratory tech...
Bacterial cultu...
Backgrounds of ...
Colonies of bac...
Air bubbles ins...
Backgrounds of ...
Backgrounds of ...
Backgrounds of ...
cultivation of ...
Hands holding a...
Backgrounds of ...
Orange agar pla...
A researcher ca...
Mixed of bacter...
Backgrounds of ...
A researcher in...
Petri dishes wi...
Listeria, bacte...
Bacterial colon...
Laboratory tech...
Hand in glove h...
Different types...
Test tube next ...
Bacterial colon...
Microbiology la...
Backgrounds of ...
Production line...